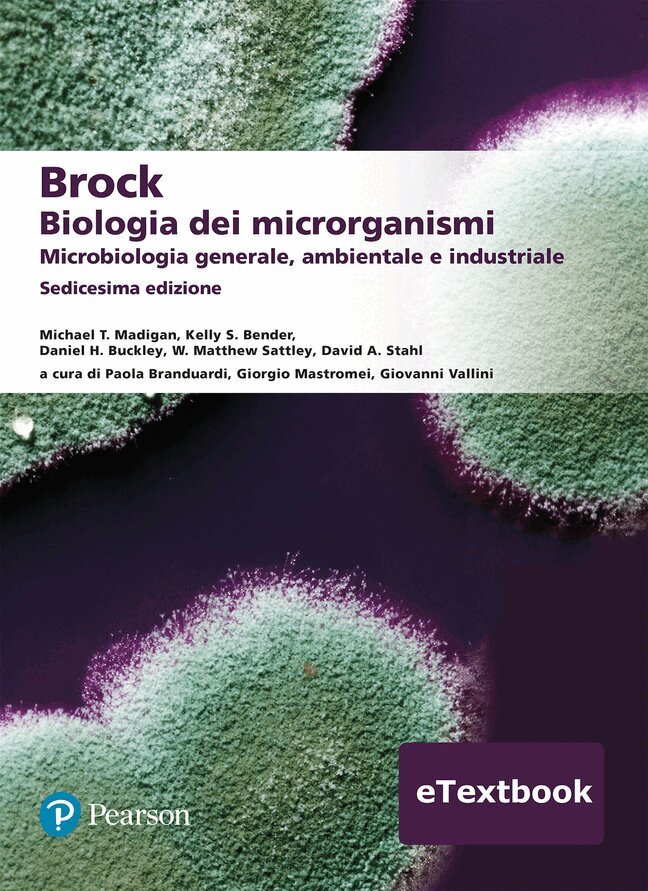

David Stahl – författare
977 kr
Get a solid understanding of the major concepts in microbiology with a textbook t hat offers cutting-edge research findings, powerful tools, and visuals.
Brock Biology of Microorganisms, Global Edition, 16th Edition is the latest version of the most authoritative textbook in the field, offering powerful, accurate, yet accessible content surrounding the basic concepts of microbiology.
The text guides you through the six major themes of microbiology — Evolution, Cell Structure and Function, Metabolic Pathways, Information Flow and Genetics, Microbial Systems, and the Impact of Microorganisms — as outlined by the American Society for Microbiology Conference on Undergraduate Education (ASMCUE).
Following a modern robust approach, the book supports your knowledge of the genomics and other omics" maze - concepts that are fundamental to the field and have transformed and revolutionised microbiology. Furthermore, it provides concrete examples of how powerful tools have allowed microbiologists to probe deeper and further into the microbial world than ever before.
2 130 kr
Skickas inom 7-10 vardagar
797 kr
Skickas inom 10-15 vardagar
765 kr
Skickas inom 10-15 vardagar
2 505 kr
Skickas inom 10-15 vardagar
2 505 kr
Skickas inom 10-15 vardagar
791 kr
Skickas inom 7-10 vardagar
840 kr
Skickas inom 7-10 vardagar
Get a solid understanding of the major concepts in microbiology with a textbook t hat offers cutting-edge research findings, powerful tools, and visuals.
Brock Biology of Microorganisms, Global Edition, 16th Edition is the latest version of the most authoritative textbook in the field, offering powerful, accurate, yet accessible content surrounding the basic concepts of microbiology.
The text guides you through the six major themes of microbiology — Evolution, Cell Structure and Function, Metabolic Pathways, Information Flow and Genetics, Microbial Systems, and the Impact of Microorganisms — as outlined by the American Society for Microbiology Conference on Undergraduate Education (ASMCUE).
Following a modern robust approach, the book supports your knowledge of the genomics and other omics" maze - concepts that are fundamental to the field and have transformed and revolutionised microbiology. Furthermore, it provides concrete examples of how powerful tools have allowed microbiologists to probe deeper and further into the microbial world than ever before.
1 232 kr
Skickas inom 7-10 vardagar
Thistitle is a Pearson Global Edition. The Editorial team at Pearson has workedclosely with educators around the world to include content which is especiallyrelevant to students outside the United States.
For courses in general microbiology.
This package includes Mastering
Authoritative. Accurate. Accessible.
Brock Biology of Microorganisms setsthe standard for accuracy, impeccable scholarship, a visually stunning artprogram, and the use of cutting-edge research to illustrate basic concepts. Thetext guides students through the six major themes of microbiology—Evolution,Cell Structure and Function, Metabolic Pathways, Information Flow and Genetics,Microbial Systems, and the Impact of Microorganisms—as outlined by the AmericanSociety for Microbiology Conference on Undergraduate Education (ASMCUE). Thisrobust and modern approach takes students through the genomics revolution and“omics” maze that has transformed microbiology and shares powerful tools thatmicrobiologists use to probe deeper and farther into the microbial world thanever before.
The 16th Edition expands the extraordinary artprogram to ensure students experience microbiology as a visual science whileproviding an overview of the microbial world with basic principles thatstudents all need to master. Each chapter's theme focuses on a recent discoverythat connects students with the most current science and engages them withexciting, real-world topics.
Reach every student with PearsonMastering Microbiology
Mastering® empowers you to reach every student. This flexibledigital platform combines unrivaled content, online assessments, andcustomizable features so you can personalize learning and improve results, onestudent at a time.
Pearson Mastering Microbiology should only be purchased when required by aninstructor. Please be sure you have the correct ISBN and Course ID.Instructors, contact your Pearson representative for more information.
1 064 kr
Skickas inom 7-10 vardagar
Get a solid understanding of the major concepts in microbiology with a textbook t hat offers cutting-edge research findings, powerful tools, and visuals.
Brock Biology of Microorganisms, Global Edition, 16th Edition is the latest version of the most authoritative textbook in the field, offering powerful, accurate, yet accessible content surrounding the basic concepts of microbiology.
The text guides you through the six major themes of microbiology — Evolution, Cell Structure and Function, Metabolic Pathways, Information Flow and Genetics, Microbial Systems, and the Impact of Microorganisms — as outlined by the American Society for Microbiology Conference on Undergraduate Education (ASMCUE).
Following a modern robust approach, the book supports your knowledge of the genomics and other omics" maze - concepts that are fundamental to the field and have transformed and revolutionised microbiology. Furthermore, it provides concrete examples of how powerful tools have allowed microbiologists to probe deeper and further into the microbial world than ever before.
877 kr
Läs direkt efter köp
This book provides a comprehensive analysis of major works in Japanese literature and film through the interpretive lens of trauma and PTSD studies. Focusing critical attention on the psychodynamics and enduring psychosocial aftereffects of social trauma, it also evaluates the themes of dissociation, failed mourning, and psychological defence fantasies.
Building on earlier studies, this book emphasizes the role of protagonists in managing to effect partial recovery by composing memoirs in which they transform dissociated traumatic memory into articulate, narrative memory or bring about advanced recovery by pioneering alternative means of orally communicating, working through, and overcoming debilitating personal histories of traumatization and victimization. In so doing, Stahl also demonstrates that what holds true on the individual and microcosmic level, also does so on the collective and macrocosmic level.
This new critical approach sheds important new light on canonical Japanese novels and films and enables recognition and appreciation of integral psychosocial aspects of these traumatic narratives. As such, the book will be of huge interest to students and scholars of Japanese film and literature, as well as those of trauma studies.
877 kr
Läs direkt efter köp
This book provides a comprehensive analysis of major works in Japanese literature and film through the interpretive lens of trauma and PTSD studies. Focusing critical attention on the psychodynamics and enduring psychosocial aftereffects of social trauma, it also evaluates the themes of dissociation, failed mourning, and psychological defence fantasies.
Building on earlier studies, this book emphasizes the role of protagonists in managing to effect partial recovery by composing memoirs in which they transform dissociated traumatic memory into articulate, narrative memory or bring about advanced recovery by pioneering alternative means of orally communicating, working through, and overcoming debilitating personal histories of traumatization and victimization. In so doing, Stahl also demonstrates that what holds true on the individual and microcosmic level, also does so on the collective and macrocosmic level.
This new critical approach sheds important new light on canonical Japanese novels and films and enables recognition and appreciation of integral psychosocial aspects of these traumatic narratives. As such, the book will be of huge interest to students and scholars of Japanese film and literature, as well as those of trauma studies.
922 kr
Läs direkt efter köp
Japanese literature and film have frequently been approached using lenses such as language, genre and ideology. Yet, despite a succession of major social traumas that have marked, and in many ways shaped and defined much of modern Japan, Japanese fiction and cinema have not often been examined psychoanalytically.
In this book, David Stahl conducts in-depth readings and interpretations of a set of Japanese novels and film. By introducing the methodology of trauma/PTSD studies, Stahl seeks to provide a better understanding of the insights of Japanese writers and directors into their societies, cultures and histories. In particular, by building on the work of practitioner-theoreticians, such as Pierre Janet and Judith Herman, Stahl analyses a number of key texts, including Kawabata Yasunari’s Sleeping Beauties (1961), Enchi Fumiko’s Female Masks (1958) and Imamura Sho- hei’s Vengeance is Mine (1979). Consequently, through using concepts of social trauma, dissociation, failed mourning, revenge and narrative memory, this book sheds new light on the psychological aftereffects and transgenerational legacies of trauma depicted in Japanese works.
Trauma, Dissociation and Re-enactment in Japanese Literature and Film will be of interest to students and scholars of Japanese Literature and Cinema, as well as those interested in Japanese History and Trauma Studies.
914 kr
Läs direkt efter köp
Japanese literature and film have frequently been approached using lenses such as language, genre and ideology. Yet, despite a succession of major social traumas that have marked, and in many ways shaped and defined much of modern Japan, Japanese fiction and cinema have not often been examined psychoanalytically.
In this book, David Stahl conducts in-depth readings and interpretations of a set of Japanese novels and film. By introducing the methodology of trauma/PTSD studies, Stahl seeks to provide a better understanding of the insights of Japanese writers and directors into their societies, cultures and histories. In particular, by building on the work of practitioner-theoreticians, such as Pierre Janet and Judith Herman, Stahl analyses a number of key texts, including Kawabata Yasunari’s Sleeping Beauties (1961), Enchi Fumiko’s Female Masks (1958) and Imamura Sho- hei’s Vengeance is Mine (1979). Consequently, through using concepts of social trauma, dissociation, failed mourning, revenge and narrative memory, this book sheds new light on the psychological aftereffects and transgenerational legacies of trauma depicted in Japanese works.
Trauma, Dissociation and Re-enactment in Japanese Literature and Film will be of interest to students and scholars of Japanese Literature and Cinema, as well as those interested in Japanese History and Trauma Studies.
221 kr
Skickas inom 5-8 vardagar
137 kr
Skickas inom 5-8 vardagar
183 kr
Skickas inom 5-8 vardagar
441 kr
Skickas inom 7-10 vardagar
Accesso per 12 mesi a Pearson eTextbook, la versione digitale del testo, arricchita da funzionalità che ne favoriscono l’accessibilità e consentono di:
effettuare lettura audio digitalizzata inserire note e segnalibri, anche su smartphone e tablet generare flashcard cercare parole o concetti nel testo modificare carattere e colore dello sfondo tradurre porzioni di testo in 100+ linguePearson eTextbook è integrato da AI Study Tool, uno strumento di intelligenza artificiale che offre supporto immediato per generare:
spiegazioni e approfondimenti riassunti personalizzati per un ripasso più efficace quiz interattivi per verificare la preparazione